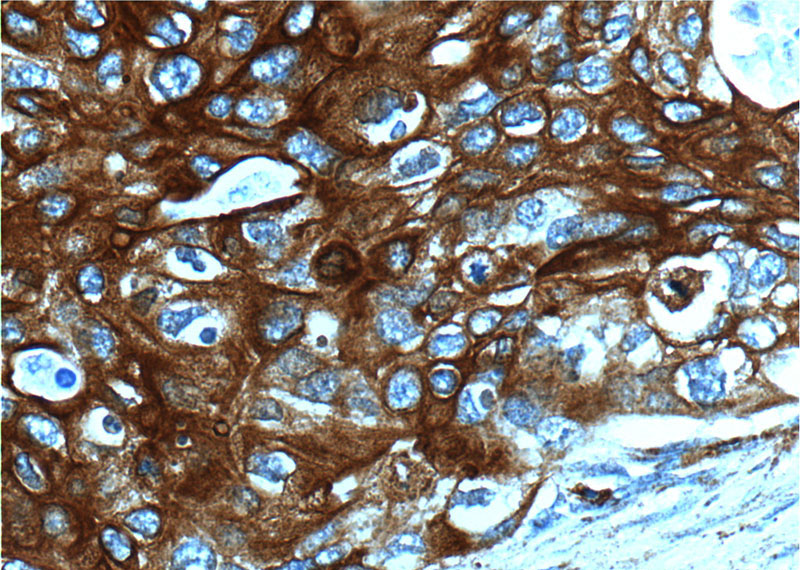
Immunohistochemistry of paraffin-embedded human cervical cancer tissue slide using Catalog No:109790(KRT13 Antibody) at dilution of 1:200 (under 40x lens).

-
Product Name
Cytokeratin 13 antibody
- Documents
-
Description
Cytokeratin 13 Rabbit Polyclonal antibody. Positive WB detected in A431 cells, HEK-293 cells, mouse skin tissue. Positive IP detected in A431 cells. Positive IF detected in A431 cells. Positive IHC detected in human cervical cancer tissue, human breast cancer tissue, human lung cancer tissue, human nephroblastoma tissue, human oesophagus tissue. Observed molecular weight by Western-blot: 50 kDa
-
Tested applications
ELISA, WB, IP, IHC, IF
-
Species reactivity
Human,Mouse,Rat; other species not tested.
-
Alternative names
CK 13 antibody; CK13 antibody; Cytokeratin 13 antibody; K13 antibody; keratin 13 antibody; KRT13 antibody
-
Isotype
Rabbit IgG
-
Preparation
This antibody was obtained by immunization of Cytokeratin 13 recombinant protein (Accession Number: NM_153490). Purification method: Antigen affinity purified.
-
Clonality
Polyclonal
-
Formulation
PBS with 0.1% sodium azide and 50% glycerol pH 7.3.
-
Storage instructions
Store at -20℃. DO NOT ALIQUOT
-
Applications
Recommended Dilution:
WB: 1:500-1:5000
IP: 1:500-1:5000
IHC: 1:50-1:500
IF: 1:20-1:200
-
Validations

A431 cells were subjected to SDS PAGE followed by western blot with Catalog No:109790(KRT13 antibody) at dilution of 1:1000

Immunohistochemistry of paraffin-embedded human cervical cancer tissue slide using Catalog No:109790(KRT13 Antibody) at dilution of 1:200 (under 10x lens).
Immunohistochemistry of paraffin-embedded human cervical cancer tissue slide using Catalog No:109790(KRT13 Antibody) at dilution of 1:200 (under 40x lens).

Immunofluorescent analysis of (-20oc Ethanol) fixed A431 cells using Catalog No:109790(KRT13 Antibody) at dilution of 1:50 and Alexa Fluor 488-congugated AffiniPure Goat Anti-Rabbit IgG(H+L)

IP Result of anti-KRT13 (IP:Catalog No:109790, 4ug; Detection:Catalog No:109790 1:1000) with A431 cells lysate 2400ug.
-
Background
Keratin 13 is a member of the keratin family. The keratins are intermediate filament proteins responsible for the structural integrity of epithelial cells and are subdivided into cytokeratins and hair keratins. Most of the type I cytokeratins consist of acidic proteins which are arranged in pairs of heterotypic keratin chains. This type I cytokeratin is paired with keratin 4 and expressed in the suprabasal layers of non-cornified stratified epithelia. Mutations in keratin 13 gene and keratin 4 have been associated with the autosomal dominant disorder White Sponge Nevus. The type I cytokeratins are clustered in a region of chromosome 17q21.2.
-
References
- Dvorak A, Tilley AE, Shaykhiev R, Wang R, Crystal RG. Do airway epithelium air-liquid cultures represent the in vivo airway epithelium transcriptome? American journal of respiratory cell and molecular biology. 44(4):465-73. 2011.
- Jaworski CJ, Aryankalayil-John M, Campos MM. Expression analysis of human pterygium shows a predominance of conjunctival and limbal markers and genes associated with cell migration. Molecular vision. 15:2421-34. 2009.
Related Products / Services
Please note: All products are "FOR RESEARCH USE ONLY AND ARE NOT INTENDED FOR DIAGNOSTIC OR THERAPEUTIC USE"
